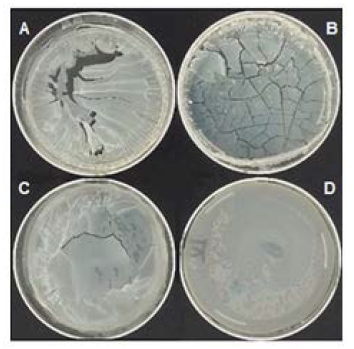
Pel&iacute;culas de alginato 1% p/V en soluci&oacute;n reguladora fosfato 20 mM a pH 6,8 con: A: 10% p/V g, B: 5%(p/v), C: 2,5%(p/v), D: 1,25%(p/v)

Artículos
Complejos vitamina E-β-lactoglobulina incluidos en películas biopoliméricas de alginato de sodio
Vitamin E-β-lactoglobulin complexes included in sodium alginate biopolymeric films
Complejos vitamina E-β-lactoglobulina incluidos en películas biopoliméricas de alginato de sodio
INNOTEC, núm. 15, pp. 44-49, 2018
Laboratorio Tecnológico del Uruguay

Esta obra está bajo una Licencia Creative Commons Atribución-NoComercial 4.0 Internacional.
Recepción: 22 Marzo 2018
Aprobación: 22 Junio 2018
Resumen: Se optimizaron las condiciones para la preparación de películas biopoliméricas capaces de encapsular los valores diarios máximos recomendados de la vitamina liposoluble E (α-tc), incorporando nanocomplejos formados por la proteína láctea beta lactoglobulina (β-lg) y la vitamina en soluciones alginato de sodio (AS), a una relación β-lg/AS determinada previamente. En primer término, se estudió por turbidimetría la interacción entre β-lg (nativa y desnaturalizada por calor) con α-tc, a diferentes pHs, y se comprobó la eficacia de β-lg nativa a pH 6,80 para solubilizar la α-tc en soluciones acuosas. Se realizaron ensayos de opacidad y color de las películas y no se encontraron diferencias por la incorporación del α-tc. Se evaluó por HPLC la integridad de la estructura de α-tc en los nanocomplejos formados en soluciones acuosas y en las películas de alginato a lo largo de un período de tiempo. La película seca mejoró la protección de la estructura del α-tc al ser expuesta al oxígeno del aire y luz controlada, efecto atribuible a la barrera al oxígeno y luz ultravioleta (UV) que ofrecen las películas secas de polisacáridos.
Palabras clave: Beta lactoglobulina, nano complejos, películas, alginato de sodio.
Abstract: In order to obtain dried films capable of encapsulating the maximum recommended daily values of fat-soluble vitamin E (α-tc), nanocomplexes between beta-lactoglobulin (β-lg), the major whey protein, and the vitamin were incorporated into sodium alginate (AS) solutions, to previously determined β-lg / AS ratio. The interaction between native and heat-treated protein with vitamin was studied by turbidimetry at different pH values. Native β-lg increased solubility α-tc in aqueous solutions at pH 6.80. Opacity and color tests to all films were carried out and no differences were found due to the incorporation of α-tc. Dry films improved the protection of α-tc structure when exposed to oxygen from the air and controlled light (measured by HPLC). This effect was attributable to the oxygen and ultraviolet light (UV) barrier exerted by the polysaccharide matrix.
Keywords: Beta lactoglobulin, Nanocomplexes, films, sodium alginate.
Introducción
Algunos desafíos de la industria alimentaria son: prolongar la vida útil de los alimentos, lograr incorporar en el alimento nutrientes o sustancias bioactivas y controlar su posterior liberación en sitios específicos del organismo (Tavares, et al., 2014). Los complejos formados por la interacción de proteínas con polisacáridos, como pectina o alginato, son capaces de incorporar vitaminas (Jones, et al., 2009; Zimet y Livney, 2009; Ron, et al., 2010; Fioramonti, et al., 2014). Así, el estudio y caracterización de la interacción de vitaminas hidrofóbicas con proteínas como la β-lg y su posterior incorporación en matrices biopoliméricas sólidas de alginato formaría un sistema capaz de proteger la estructura de la vitamina por un período de tiempo razonable y, a su vez, brindaría importante información sobre un modo de incorporación, en un futuro, de vitaminas a alimentos.
La β-lg es la proteína mayoritaria del lactosuero. Ha sido ampliamente estudiada por su capacidad de ligar compuestos hidrofóbicos y anfifílicos como saborizantes, vitaminas, ácidos grasos y polifenoles (Livney, 2010). En su estado nativo presenta diferentes sitios capaces de fijar ligandos hidrofóbicos (ácidos grasos, vitaminas liposolubles), al tiempo que, bajo determinadas condiciones, es capaz de autoensamblarse para formar superestructuras oligoméricas (Báez, et al., 2011) que permiten la encapsulación y el transporte de una diversidad de pequeñas moléculas (Livney, 2010) como α-tocoferol (Relkin y Shukat, 2012), aromatizantes (Giroux y Britten, 2011), entre otros. La exposición de mayor número de sitios hidrofóbicos se relaciona con su grado de desnaturalización (Busti, et al., 2000; Moro, et al., 2001; Delorenzi, 2005).
El calentamiento a temperaturas superiores a 80 °C provoca cambios en la estructura secundaria y terciaria de la proteína, ocasionando la pérdida de la cavidad interna aunque conserva parte de su actividad encapsulante. Esto último sugiere que se crean nuevos sitios de unión tras exponer al solvente otros residuos hidrofóbicos (Mousavi, et al., 2008).
La interacción de la proteína con vitaminas hidrofóbicas para incorporarlas en alimentos ha sido estudiada por otros autores (Liang, et al., 2011; Liang y Subirade, 2012; Relkin, et al., 2012; Relkin, et al., 2014), quienes analizaron las características de la fijación, la influencia de las condiciones del medio y la estabilidad de los complejos.
La vitamina E pertenece a una familia de compuestos poliprenoides. En su estado natural presenta ocho isómeros, de los cuales el α-tc es el más abundante, biodisponible y ópticamente activo. Dentro de la amplia variedad de beneficios que aporta su ingesta, se destaca su poder antioxidante, que previene la propagación de radicales libres cuyo rol es fundamental en enfermedades crónicas y cardiovasculares. Se acepta que 20 mg/día sería el máximo valor de ingesta que podría ser administrado como suplemento (National Institute of Health, 2016). En los suplementos dietarios, el α-tc se encuentra como acetato y succinato de α-Tocoferol. Bajo estas formas aumenta su estabilidad, pero se reduce, aproximadamente al 30%, su absorción a nivel del intestino humano en comparación con la administración del α-tc en forma pura. Esta última opción es prácticamente inviable a causa de su hidrofobicidad y alta sensibilidad al calor, al oxígeno y a la luz.
La unión del α-tc con la β-lg produce, en el medio, distintas especies: monómeros de vitaminas hidrófobas, moléculas autoasociadas de vitaminas (nanopartículas) y complejos de proteínas y vitaminas (Liang, et al., 2011). Los complejos formados son estructuras capaces de solubilizar la vitamina en soluciones acuosas estables e incrementar su vida media, protegiéndola de factores adversos como la luz, el oxígeno y la temperatura. El enriquecimiento de alimentos con sustancias nutricionales hidrofóbicas presenta un especial desafío, debido a la dificultad de incorporar estos compuestos a sistemas acuosos. El vehículo ideal para este fin debe ser de origen natural, económico y capaz de solubilizar y proteger al bioactivo.
Los alginatos son una familia de polisacáridos binarios lineales cuya estructura consta de “m” uniones (1→4) β-D-manurónico y “n” ácido α-l-Gulurónico. Este polímero debe su carácter polianiónico a los grupos carboxilo (pKa = 3,5) que aparecen a lo largo de la cadena. La composición y extensión de las secuencias manurónico/gulurónico y el peso molecular determinan las propiedades físicas de los alginatos (Romero, et al., 2013).
La forma en la que interaccionan los alginatos y la β-lg varía de acuerdo al pH del medio en que se encuentren. A pH neutro, tanto el polisacárido como la proteína presentan carga negativa y ambos permanecen solubles en medio acuoso. Cerca del punto isoeléctrico de la proteína (pH 4,7 - 5,2) se forman complejos solubles sobre la base de interacciones electrostáticas y, a pH inferior a 4,7 las interacciones se ven notablemente incrementadas dando lugar a la agregación de partículas (de Kruif, et al., 2004; Qomarudin, et al., 2015).
En la actualidad se busca incorporar los beneficios provistos por los alginatos en los micro encapsulados para protegerlos de factores adversos como el oxígeno, el calor, la humedad (Ron, et al., 2010) o la radiación UV (Draget, 2009; Rhim, 2004; Pereira, et al., 2013).
Materiales y métodos
Reactivos
Se prepararon soluciones reguladoras de fosfato de sodio (Pi) 20 mM de pH 3,00 y 6,80 y los reactivos utilizados fueron de grado analítico. Se utilizó β-lg Sigma Chemicals Co. (St. Louis, MO, USA) de origen bovino. Las soluciones se prepararon disolviendo, sin ningún otro tipo de purificación, 25 mg de la droga por pesado directo en 1 mL de las soluciones reguladoras, a ambos pHs, y conservadas a -20 °C hasta su utilización. Se preparó una solución madre 10 mM, α-Tocoferol Sigma Chemicals Co. (St. Louis, MO, USA) en etanol absoluto Cicarelli (Rosario, Argentina) y se la mantuvo conservada en frasco color caramelo en atmósfera de nitrógeno y al abrigo de la luz. Se elaboraron soluciones madre 2% peso en volumen (% p/V) de AS Sigma Chemicals Co. (St. Louis, MO, USA) PM: 100.000 de viscosidad media, disolviendo 4 g por pesado directo de la droga sólida en 200 mL de las soluciones reguladoras de pH 3,00 y 6,80. Las soluciones obtenidas se calentaron por 5 minutos a 60 °C y se eliminaron los gases por aplicación de vacío.
Desnaturalización por tratamiento térmico de la β-lg
Soluciones de β-lg 20 µM en buffer Pi 20 mM pH 3,00 y pH 6,80 se calentaron a 85 °C durante 5 minutos en baño termostático. Concluido el procedimiento, las muestras fueron llevadas a temperatura ambiente y congeladas a -20 °C.
Turbidimetría
La turbidez se determinó por medio de medidas de absorbancia (Abs) a 500 nm en un espectrofotómetro Jasco V-500 (Jasco International Co., Ltd., Tokyo Japan). Cada una de las muestras fue medida por triplicado. Para transformar los valores de absorbancia en turbidez, se utilizó la ecuación:
 (1)
(1)Interacción de la β-lg con α-tc
Medidas de la turbidez de la α-tc
Se midieron las turbideces iniciales de soluciones de β-lg 20 µM pH 3,00 y 6,80, a las que se le fueron agregando alícuotas de una solución madre de α-tc 10 mM, en un rango de 0 - 500 µM, a 25 °C. Se realizaron los blancos de proteína correspondientes para cada pH. De igual manera se trabajó con la β-lg 20 µM a pH 3,00 y 6,80 desnaturalizadas por calor. La solución de β-lg a pH 3,00 gelificó y fue descartada. Para cada tipo de muestra las medidas se realizaron por triplicado.
Obtención de películas de AS~β-lg /α-tc
Películas de AS~β-lg y AS~β-lg /α-tc
Se prepararon películas con distintas relaciones proteína-alginato. 5 mL de solución de AS 2% p/V en buffer Pi 20 mM pH 6,80 se mezclaron con 5 mL de soluciones formadas por buffer Pi 20 mM pH 6,80 y distintas cantidades de β-lg. Se probaron cantidades de 1 g, 0,5 g, 0,25 g y 0,125 g de β-lg.
Para obtener las películas con la vitamina adicionada se disolvieron 20 mg de α-tc en 0,5 mL de alcohol absoluto, luego se llevó a volumen de 5 mL con buffer Pi 20 mM pH 6,80 conteniendo disueltos 0,125 g de β-lg, y se completaron los 10 mL de sistema añadiendo un volumen de 5 mL de solución de AS 2 % p/V en buffer Pi 20 mM pH 6,80 (Soazo, et al., 2015a), homogeneizando por agitación manual suave.
Las mezclas obtenidas se vertieron en placas de Petri de 5 cm de diámetro y, para evitar la acción del aire y la luz, estas se introdujeron dentro de una caja plástica cerrada con conductos de entrada y salida por los que se aplicó un flujo de nitrógeno. Por último, la caja plástica se colocó dentro de una estufa, donde se secaron las muestras durante 6 h a 40 °C. Las películas obtenidas se guardaron en bolsas de polietileno cerradas al vacío y al abrigo de la luz en una cámara de control de humedad (Pharma SCT, Buenos Aires, Argentina) a 55% de humedad y 25 °C de temperatura hasta su utilización.
Opacidad y color
Se determinó la opacidad de las distintas películas siguiendo la metodología propuesta por (Siripatrawan y Harte, 2010). Se tomaron cinco muestras rectangulares (10 mm × 30 mm) de diferentes partes de una película y se ubicaron en el lado interno de una celda de espectrofotómetro Jasco V-500 (Jasco International Co., Ltd., Tokyo, Japan). La absorbancia de luz de las muestras de películas fue medida a una longitud de onda de 600 nm (Abs600). La opacidad se calculó usando la ecuación:

Donde L es el espesor de la película en mm. Esta operación se repitió con tres películas diferentes de cada tipo. Para el estudio del color se determinaron los parámetros L* (claridad), a* (rojo-verde), b* (amarillo-azul) siguiendo el diseño descrito por Mendoza y Aguilera (2004) con algunas modificaciones (Soazo, et al., 2015b).
Los valores de ∆E (diferencia de color total), definido como las diferencias entre los parámetros de color de la muestra y un blanco estándar, se calcularon siguiendo los trabajos de Yam y Papadakis (2004) y Soazo et al. (2015a). Todas las medidas se realizaron por quintuplicado.
Estudio de la degradación de α-tc como función del tiempo de exposición al oxígeno del aire y radiación UV mediante HPLC
Para estudiar la degradación del α-tc por efecto de la acción del oxígeno y de la radiación lumínica en función del tiempo de exposición las distintas muestras fueron divididas en tres sistemas diferentes: A, B y C.

Figura 1.
Representación esquemática de la experiencia realizada en el estudio de la degradación del α-tc.
Sistema A: Solución de α-tc 20mg/100mL en etanol absoluto (Solución A).
Sistema B: Solución de nanocomplejo α-tc 20mg/100mL, β-lg 1,25% p/V en Pi 20 mM pH 6,80 (Solución B).
Ambos sistemas fueron conservados en atmósfera de nitrógeno y oscuridad (para evitar la acción del oxígeno y la fotólisis) hasta su utilización.
Sistema C: Película de AS~β-lg/α-tc. Se utilizaron siete películas diferentes.
Para el estudio del sistema C cada día se preparó una solución disolviendo una película en 100 mL de una mezcla 1:1 de buffer fosfato 20 mM pH 6,80: etanol absoluto (Solución C). El protocolo de trabajo se presenta en la Figura 1.
Los tres sistemas fueron expuestos durante siete días a la acción del oxígeno del aire ambiental y de una radiación lumínica (fluorescente blanco de 36 Vatios con un flujo luminoso (F) de 3000 lm) a una iluminancia (Ev) de 200 lx, medida con luxómetro Amprobe LM-100 (Amprobe Test Tools, Glottertel, Germany) resolución 0,1 lx. La temperatura se fijó en 25 °C.
Cromatografía líquida de alta resolución
Diariamente y durante siete días se le extrajo a cada una de las tres soluciones formadas el α-tc, según el método propuesto por Liang et al. (2011). Cada muestra obtenida fue luego inyectada en un cromatógrafo HPLC Shimadzu LC-10 (Kyoto, Japan), anexado a una columna LC-18 (25cm x 4,6mm) SUPELCOSIL (Sigma-Aldrich, St. Louis, MO, USA): tamaño de partícula 5 µm, tamaño de poro 100 Ǻ. Las condiciones cromatográficas fueron: detector UV, λ= 292 nm; fase móvil isocrática, metanol absoluto; velocidad de flujo 1 mL/min; temperatura de la columna 45 °C. Las mediciones se realizaron por triplicado.
Resultados y Discusión
Interacción de la β-lg con α-tc
Medidas de turbidez de α-tc a distintos valores de pH
En el Gráfico 1 se representan los valores de turbidez para los sistemas β-lg (nativa y desnaturalizada)/α-tc comparados con α-tc sola (los resultados a pH 3,00 y 6,80 fueron similares, razón por la cual se graficó la curva obtenida a pH 6,80). La turbidez de estos sistemas es menor que la observada en las respectivas dispersiones sin proteína. Esto se debe a que en medio acuoso el α-tc se uniría a la proteína formando un complejo soluble, hecho que podría tomarse como un indicador de la eficiencia de la proteína para vehiculizar un compuesto lipofílico.
A pH 3,00 el sistema formado presenta mayor turbidez que a pH 6,80. Este comportamiento podría adjudicarse a la menor cantidad de sitios de fijación que expondría la proteína al estar principalmente como monómero. La proteína a pH 6,80 presenta una estructura compuesta por un 11% de monómeros y un 89% de dímeros, motivo por el cual expondría mayor cantidad de sitios de fijación (Moro, et al., 2011), e incluso también pueden aparecer otros sitios hidrofóbicos inespecíficos ubicados en la superficie proteica (Liang, et al., 2012).
Los complejos β-lg (desnaturalizada)/α-tc presentaron mayor turbidez que β-lg (nativa)/α-tc. Este hecho se debería a la pérdida de sitios de fijación cuando es desnaturalizada por calentamiento (Busti, et al., 2005), por lo cual se puede descartar al complejo β-lg (desnaturalizada)/α-tc a pH 6,80 como sistema de estudio.

Gráfico 1.
Turbidez (τ) de soluciones de α-tc (punto verde), α-tc con β-lg (desnaturalizada) en buffer Pi 20 mM pH 6,80 (punto rojo), α-tc con β-lg en buffer Pi 20 mM pH 6,80 (punto azul), α-tc con β-lg en buffer Pi 20 mM pH 3,0 (punto negro). Concentración de la proteína 20 µM.
Obtención de películas de AS~β-lg/α-tc
La Figura 2 muestra las películas obtenidas para distintas relaciones proteína-alginato. Para valores de 1 g, 0,5 g, y 0,25 g de β-lg resultaron quebradizas, mientras que la de 0,125 g de β-lg se mostró homogénea, maleable y traslúcida, características deseables para su posterior uso como vehículo de α-tc. Esto puede deberse a que, si bien a pH 6,8 ambas especies tienen cargas netas negativas y entre ellas se generan fuerzas repulsivas electrostáticas que las mantienen en solución (Qomarudin, et al., 2015), la calidad de las películas formadas al secar dichas soluciones es dependiente de la masa de proteína utilizada para una determinada cantidad de AS.
Figura 2.
Películas de alginato 1% p/V en solución reguladora fosfato 20 mM a pH 6,8 con: A: 10% p/V g, B: 5%(p/v), C: 2,5%(p/v), D: 1,25%(p/v)
Las películas AS~β-lg/α-tc, con 20 mg (por película) de α-tc, correspondiente con la ingesta diaria máxima recomendada, no variaron su calidad, fueron homogéneas y maleables, y presentaron un espesor de entre 30 y 60 µm (Figura 3).

Figura 3.
Película AS~β-lg/α-tc, en solución reguladora fosfato 20 mM a pH 6,8. Cantidad de alginato: 0,100 g. Cantidad de β-lg: 0,125 g. Cantidad de α-tc: 20 mg.
Opacidad y color
El estudio de opacidad y color de las películas se ve reflejado en la Tabla 1, donde se evidencia que el agregado de la vitamina, en forma de complejo con la proteína, no altera sus características ópticas.

Estudio de la degradación de α-tocoferol
En el Gráfico 2 se presentan las curvas de degradación de α-tc por efecto de la acción del oxígeno del aire e intensa radiación lumínica en función del tiempo de exposición.

Gráfico 2.
Degradación de α-tc a distintos tiempos de almacenaje, solución de etanol (punto negro), solución de β-lg/α-tc (punto rojo) y películas de AS~β-lg/α-tc (punto azul).
El análisis del Gráfico 2 muestra que al someter el α-tc a condiciones oxidantes su estructura se va degradando.
Al séptimo día, la vitamina disuelta en alcohol mantiene intacto solamente un 14 ± 4,6% de su estructura (curva en color negro).
La β-lg la protege, manteniendo intacto un 44 ± 4,0% de su estructura, por la formación de los nanocomplejos solubles (curva en color rojo).
La muestra proveniente de la película mantiene un 74,5 ± 4,5% de su estructura original intacta (curva color azul). Esto indica que la presencia de AS en la película aumenta el efecto protector que la β-lg ya ejerce al formar el complejo, posiblemente por una acción sinérgica con la proteína.
No se realizaron estudios de absorción de agua debido a que las películas no mostraron cambios macroscópicos en su calidad luego de estar expuestas al aire ambiental durante el tiempo de estudio.
Conclusión
Se formaron nanocomplejos por fijación de α-tc a β-lg en sitios específicos e inespecíficos de su superficie a pH 6,80. Las películas obtenidas permitieron incorporar el complejo β-lg/α-tc (respetando la concentración de α-tc correspondiente a la ingesta máxima diaria), y se lograron estructuras homogéneas, traslúcidas y maleables, sin que el agregado de vitamina afecte sus propiedades. En cuanto a la estabilidad del α-tc, las películas demostraron proteger su integridad ante la acción de agentes oxidantes. La aplicación de estas películas puede resultar útil para mantener la estructura de la vitamina conservada en el tiempo hasta su incorporación en alimentos o preparaciones farmacéuticas.
Referencias
Báez, G. D., Moro, A., Ballerini, G. A., Busti, P. A. y Delorenzi, N. J., 2011. Comparison between structural changes of heat-treated and transglutaminase cross-linked betalactoglobuline and their effects on foaming properties. En: Food Hydrocolloids, 25(7), pp.1758–1765.
Busti, P., Gatti, C. A. y Delorenzi, N. J., 2000. Some aspects of β-lactoglobulin structural properties in solution studied by fluorescence quenching. En: International Journal of Biological Macromolecules, 23(1998), pp.143–148.
Busti, P., Gatti, C. A. y Delorenzi, N. J., 2005. Thermal unfolding of bovine β-lactoglobulin studied by UV spectroscopy and fluorescence quenching. En: Food Research International, 38(5), pp.543–550.
de Kruif, C. G., Weinbreck, F. y de Vries, R., 2004. Complex coacervation of proteins and anionic polysaccharides. En: Current Opinion in Colloid & Interface Science, 9(5), pp.340–349.
Delorenzi, N. J., 2005. Beta-lactoglobulin conformational changes studied by fluorescence quenching. En: Riley, Arthur, P., ed., 2005. Food research, safety and policies. New York: Nova Science Publishers. pp.169–183
Draget, K. I., 2009. Alginates. En: Glyn, O. Phillips, Williams, P. A. Handbook of hydrocolloids. 2a ed. London: Woodhead Publishing. pp.807–828
Fioramonti, S. A., Pérez, A. A., Aríngoli, E. E., Rubiolo, A. C. y Santiago, L. G., 2014. Food hydrocolloids design and characterization of soluble biopolymer complexes produced by electrostatic self-assembly of a whey protein isolate and sodium alginate. En: Food Hydrocolloids, 35, pp.129–136.
Giroux, H. J. y Britten, M., 2011. Encapsulation of hydrophobic aroma in whey protein nanoparticles. En: Journal of Microencapsulation, 28(5), pp.337–343.
Jones, O. G., Decker, E. A. y McClements, D. J., 2009. Formation of biopolymer particles by thermal treatment of β-lactoglobulin–pectin complexes. En: Food Hydrocolloids, 23(5), pp.1312–1321.
Liang, L. y Subirade, M., 2012. Study of the acid and thermal stability of β-lactoglobulin-ligand complexes using fluorescence quenching. En: Food Chemistry, 132(4), pp.2023–2029.
Liang, L., Tremblay-Hébert, V. y Subirade, M., 2011. Characterisation of the b-lactoglobulin/a-tocopherol complex and its impact on a-tocopherol stability. En: Food Chemistry, 126(3), pp.821–826.
Livney, Y. D., 2010. Milk proteins as vehicles for bioactives. En: Current Opinion in Colloid & Interface Science, 15(1), pp.73–83.
Mendoza, F. y Aguilera, J. M., 2004. Application of image analysis for classification of ripening bananas. En: Journal of Food Science, 69(9), pp.474-477.
Moro, A., Báez, G. D., Busti, P. A., Ballerini, G. A. y Delorenzi, N. J., 2011. Effects of heat-treated β-lactoglobulin and its aggregates on foaming properties. En: Food Hydrocolloids, 25(5), pp.1009–1015.
Moro, A., Gatti, C. y Delorenzi, N., 2001. Hydrophobicity of whey protein concentrates measured by fluorescence quenching and its relation with surface functional properties. En: Journal of Agricultural and Food Chemistry, 49(10), pp.4784–4789.
Mousavi, S. H.-A., Bordbar, A.-K. y Haertlé, T., 2008. Changes in structure and in interactions of heat-treated bovine beta-lactoglobulin. En: Protein and Peptide Letters, 15(8), pp.818-825.
National Institute of Health, Office of Dietary Supplements, 2016. Vitamina E: hoja informativa para consumidores [En línea]. Besthesda: NIH. [Consulta: 13/2/2017]. Disponible en: https://ods.od.nih.gov/factsheets/VitaminE-DatosEnEspanol/
Pereira, R., Carvalho, A., Vaz, D. C., Gil, M. H., Mendes, A. y Bártolo, P., 2013. Development of novel alginate based hydrogel films for wound healing applications. En: International Journal of Biological Macromolecules, 52, pp.221–230.
Qomarudin, Q., Orbell, J., Ramchandran, L., Gray, S. R., Stewart, M. B. y Vasiljevic, T., 2015. Properties of beta-lactoglobulin / alginate mixtures as a function of component ratio, pH and applied shear. En: Food Research International, 71, pp.23–31.
Relkin, P. y Shukat, R., 2012. Food protein aggregates as vitamin-matrix carriers: Impact of processing conditions. En: Food Chemistry, 134(4), pp.2141–2148.
Relkin, P., Shukat, R. y Moulin, G., 2014. Encapsulation of labile compounds in heat- and high-pressure treated protein and lipid nanoparticles. En: Food Research International, 63, pp.9-15.
Rhim, J.W., 2004. Physical and mechanical properties of water resistant sodium alginate films. En: LWT - Food Science and Technology, 37(3), pp.323–330.
Romero, G. C. A., Malo, A. L. y Palou, E., 2013. Propiedades del alginato y aplicaciones en alimentos. En: Temas Selectos de Ingeniería de Alimentos, 7(1), pp.87–96.
Ron, N., Zimet, P., Bargarum, J. y Livney, Y. D., 2010. Betalactoglobulin-polysaccharide complexes as nanovehicles for hydrophobic nutraceuticals in non-fat foods and clear beverages. En: International Dairy Journal, 20(10), pp.686–693.
Siripatrawan, U. y Harte, B. R., 2010. Physical properties and antioxidant activity of an active film from chitosan incorporated with green tea extract. En: Food Hydrocolloids, 24, pp.770-775.
Soazo, M., Báez, G., Barboza, A., Busti, P., Rubiolo, A., Verdini, R. y Delorenzi, N., 2015a. Heat treatment of calcium alginate films obtained by ultrasonic atomizing: physicochemical characterization. En: Food Research International, 51, pp.193-199.
Soazo, M., Pérez, L., Rubiolo, A. y Verdini, R., 2015b. Prefreezing application of whey proteinbased edible coating to maintain quality attributes of strawberries. En: Intl J Food Sci Tech, 50(3), pp.605–611.
Tavares, G. M., Croguennec, T., Carvalho, A. F. y Bouhallab, S., 2014. Milk proteins as encapsulation devices and delivery vehicles: Applications and trends. En: Trends in Food Science & Technology, 37(1), pp.5–20.
Yam, K. L. y Papadakis, S. E., 2004. A simple digital imaging method for measuring and analyzing color of food surfaces. En: Journal of Food Engineering, 61, pp.137-142.
Zimet, P. y Livney, Y. D., 2009. Beta-lactoglobulin and its nanocomplexes with pectin as vehicles for ω-3 polyunsaturated fatty acids. En: Food Hydrocolloids, 23(4), pp.1120–1126.
